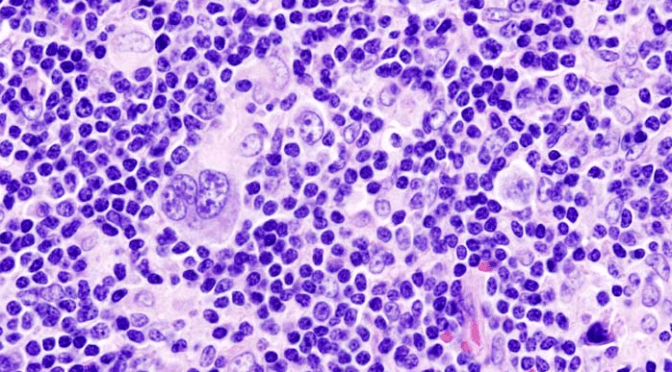

We have yet another couple of stimulating talks lined up for you all this coming Spring.
Date: Thursday 27th March
Venue: Westminster University, Cavendish Campus, 115 New Cavendish Street, London, W1W 6UW.
First up, Dr Ayoma Attygalle, a consultant histopathologist at the Royal Marsden, will talk about lymphoma from a research perspective. Her principle research area is angioimmunoblastic T-cell lymphoma.
To follow, Dr Alan Ramsay, a consultant histopathologist at University College Hospital, will be talking about haematopathological disease from a diagnostic perspective, looking at the role of the needle core biopsy.
As always, we will be providing light refreshments, CPD points, and some great discussions.
If you would like to attend, please do make sure you, or your group, register by clicking on our register button below:
We look forward to seeing you there!